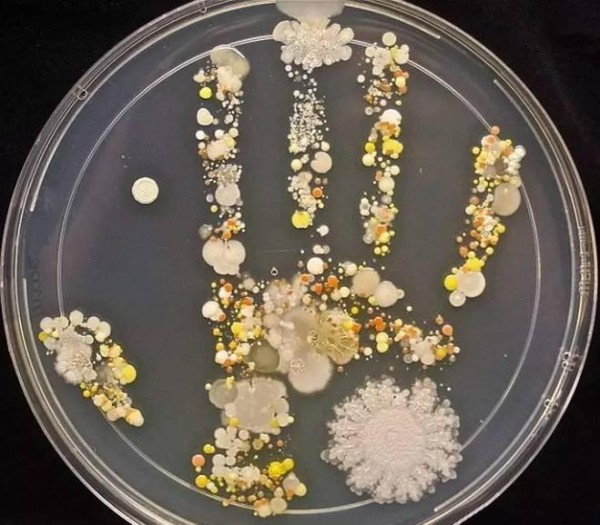

P图是万能的,但痘痘来了,我还是有小情绪!
以前都是很傻很天真的认为明星都是无痘体质,直到越来越多的女星勇敢地以素颜直面狗仔......才发现,原来皮肤差一点也并不会阻挡你的星路。

比如国民女神 Baby ,作为美图手机 M4 代言人, Baby 此前曝光的未修图的原照让我心中一惊,原来女神也是长痘的啊。

看来只要备有一款美颜相机,再多的痘也就是加一级磨皮美颜效果的事儿。(Ps:最近发现自己的自拍少了不少,想来想去大概是因为内存卸掉了美颜相机.......)

可今天想跟你们聊的不是美颜相机而是去祛痘和痘痕,是当你卸掉美颜相机,你仍能自信地玩儿自拍。
So...点进来的你,应该正在被痘痘和痘印困扰的,或者时刻都未雨绸缪着。长痘的原因、如何预防以及如何快速祛痘、去痘印是我们今天依次会讲到的四个点。
长痘的原因及预防
饮食辛辣不规律

长痘的原因那么多种,而作为一吃辣就长痘星人,袁姗姗小马甲也是为了满足自己的好吃嘴下了不少祛痘的功夫。
为什么吃辛辣容易长痘?
1、针对吃辣后一秒就能冒痘的人群,是因为辛辣会刺激我们的汗腺排出汗液,而汗液中含有油脂,可能会造成堵塞毛孔,而毛孔堵塞就引起了皮肤炎症,也就是长痘咯。
2、针对吃辣后的一段时间(几天甚至几个月)持续长痘的情况,那就是这些刺激性的食物影响了你身体的正常排毒,体内的毒素排不出去自然就表现在了我们脸上,脸色暗淡偏黄、起斑、长痘等等,不同体质的表现方式也都不同。
所以,预防措施一就是管住自己的嘴(最简单又最难的方法),特别是在这一不小心就能热炸的夏天,大多数痘痘爆发的属性都是第一种的「油炸」。
而女性长痘的另一个内在因素就是经期,每个月总有那么两三个痘准时准点来报到。
关于这些我建议小仙女们家里常备一点绿豆,煮点绿豆汤在冰箱里存着,有事没事就喝点儿,降温又排毒,就是这么简单又粗暴的亲试饮食 Tip 。
卸妆不彻底
如果你能把卸妆看得比美美的出街妆还重要,那我想你就不会长痘了......
卸妆不彻底,遗留的化妆品会造成毛孔堵塞,倒导致皮肤发炎长痘、色素累积长斑,道理都懂,可我们还是不好好卸妆。


现在的很多肌肤问题跟我们日常用的护肤、美妆是脱不了关系的,上面的 gif 都出自这段娜扎的卸妆视频,其中娜扎提到了自己整天带妆、作息不规律导致长了很多小痘痘,所以好好看,卸妆就是你抗痘的良药。
▲ 完整的卸妆教程视频
而关于卸妆产品,我们之前也储备了很多,点击回看咯~ 17款卸妆产品的使用测评,帮你找到最适合的那一个
关于祛痘的这些事儿
长痘时最忌讳的事:动手
▲ 微生物学家塔莎·斯特姆通过实验发现儿子手掌上的细菌
动不动就用你未经清洁的手触碰痘区,你的手很脏你知道的哇!
动不动就挤痘,跟玩儿打地鼠游戏似的,你出头我就挤,挤完也没有任何消毒措施。
动不动就抠未完全愈合的痘疤......
总之,既然痘已经长了,我们能做的就是管好自己的手,让痘不留痕迹地消失。
快速祛痘 Tips
没办法,在痘已经在这儿了,明天得参加派对、见男朋友、见女朋友,总之是很重要的一天,脸上绝对不能有痘!
那今晚睡觉前你需要做下面这些事 ↓
深层、彻底的洁面,这次洁面工作不能只是仪式感,必须要深刻。
a\ 用热温水润湿面部,洁面乳在手中打泡后上脸,用四支手指以画圈的方式按摩清洗
b\ 之前的热温水已经让毛孔打开,所以最后用凉水冲洗收缩毛孔
如果你已经很久没有去角质,那你可以考虑给自己来一个,手法不要太重。

然后你就可以开始快速祛痘了:
使用收敛剂
它是能沉淀组织内部分蛋白质而促使组织皱缩的药物,有消炎退肿的作用。也是短时间内祛痘的最快方法。
关于如何购买收敛剂,建议去正规医院皮肤科按医嘱拿要药。

如果没有那么严重或者紧急,我们生活中的一些食物也都是有收敛作用的,比如:香蕉皮、金缕梅(见效快)、绿茶(含有抗氧化性)、番茄(舒缓痘痘的同时有缩小毛孔的功效)。
茶树精油
在棉签上滴一滴茶树精油,涂在痘痘上,避免手直接接触,可以有杀菌抗炎的效果,以此来祛痘。
阿司匹林
将具有抗炎效果的阿司匹林片磨成粉,再调水成糊状涂在痘痘上,同样也能缓解痘痘。
牙膏
如果痘痘肿太大,小仙女们可以考虑拿出这个杀手锏了,牙膏里都含有二氧化硅,有干燥作用,第二天睡醒痘痘就脱水变小了。
划重点:在涂牙膏前先确认牙膏的成分,如果含有十二醇硫酸钠(也叫月桂醇硫酸酯钠盐)的牙膏就不要用了,这个成分对我们的皮肤有刺激。
如何去除痘痕
既然长痘已经势不可挡,那你还要顾虑到痘痘之后会不会留下痘痕了,这才是最闹心的。
痘痕的类型有三种,痘印、痘坑(下凹)和痘疤(凸起)。
痘印是由于痘痘发炎后引起的色素沉淀;
痘坑是由于痘痘严重发炎伤及到了真皮层胶原蛋白,引起皮肤表面的下凹;
痘疤则是增生性痘印,是痘痘愈合之后,形成凸起的皮肤组织增生,不过这种痘印大都是先天体质决定的。
而研究表明,2/3 肤质的痘印会在之后一年的时间中变淡褪去,但也有永久性存在的可能,而痘坑、痘疤则除了医学美容不大有逆转的可能。
去除痘痕 Tips
做好防晒工作
正常的肌肤长时间暴露在阳光中都会导致色素沉淀而长斑,更何况是本就有色素沉淀的痘痕呢?
所以在痘痘痊愈之前就要开始做好防晒工作,当然防晒是任何时间都不能忘记的事情。
淡化疤痕的食物
a\ 柠檬汁
柠檬里含有阿尔法羟基酸(AHA),涂在痘痕上可以去死皮,促进新细胞的生长,修复皮肤的弹性。同时它还可以淡化疤痕色素,也就是柠檬美白的功效。

不过这项工作尽量在晚上进行,因为涂了柠檬汁之后的皮肤对光线会变得很敏感,如果是白天涂抹记得在之后来一层防晒霜,否则就是天然增黑的效果了。
b\ 蜂蜜 + 小苏打
蜂蜜有保湿效果,同时能刺激组织再生,而蜂蜜和小苏打按 2:1 的比例调和出来可以有去角质的功效,淡化痘痕。
c\ 茶树油 or 橄榄油
茶树油抗菌,橄榄油富含维E,可以淡化疤痕。分别用这两种油进行一段时间的按摩,痘痕都可以得到缓解的。
医学美容
如果上面这些天然的物质不能解决你的痘痕,或者你想更快速的去痘印,请一定要选择正规的三甲医院。
划重点:无论是祛痘还是去痘印,小仙女们都要擦亮自己的眼睛,那些吹上天的三无祛痘产品就不要考虑了,把你去买产品的钱用在正规医院里,把看祛痘广告的时间用来遵循医嘱,合理作息,除此之外没有捷径可走咯~
最后,愿每一位小仙女的皮肤都能达到美颜相机的十级效果,晚安~
网址:P图是万能的,但痘痘来了,我还是有小情绪! https://mxgxt.com/news/view/1995566
相关内容
痘痘不好都是你挤痘痘强迫症惹的祸头上长痘痘怎么办,是有脓包痘痘的。
手贱喜欢挤痘痘,那些痘痘可以挤,哪些不能碰?
痘痘反反复复总是长,很可能是它在作祟
明星都在用的痘痘贴,真的能祛痘?
很多明星有钱为什么还是很多痘坑?痘坑能彻底治愈吗?
明星们是怎样去除痘痘的
怎么鉴别脸上痘痘是螨虫引起的还是别的什么
较真丨19岁女孩挤痘痘引发颅内感染,为什么痘痘不能乱挤?
明星长痘怎么祛痘(明星长痘痘用什么祛痘)

